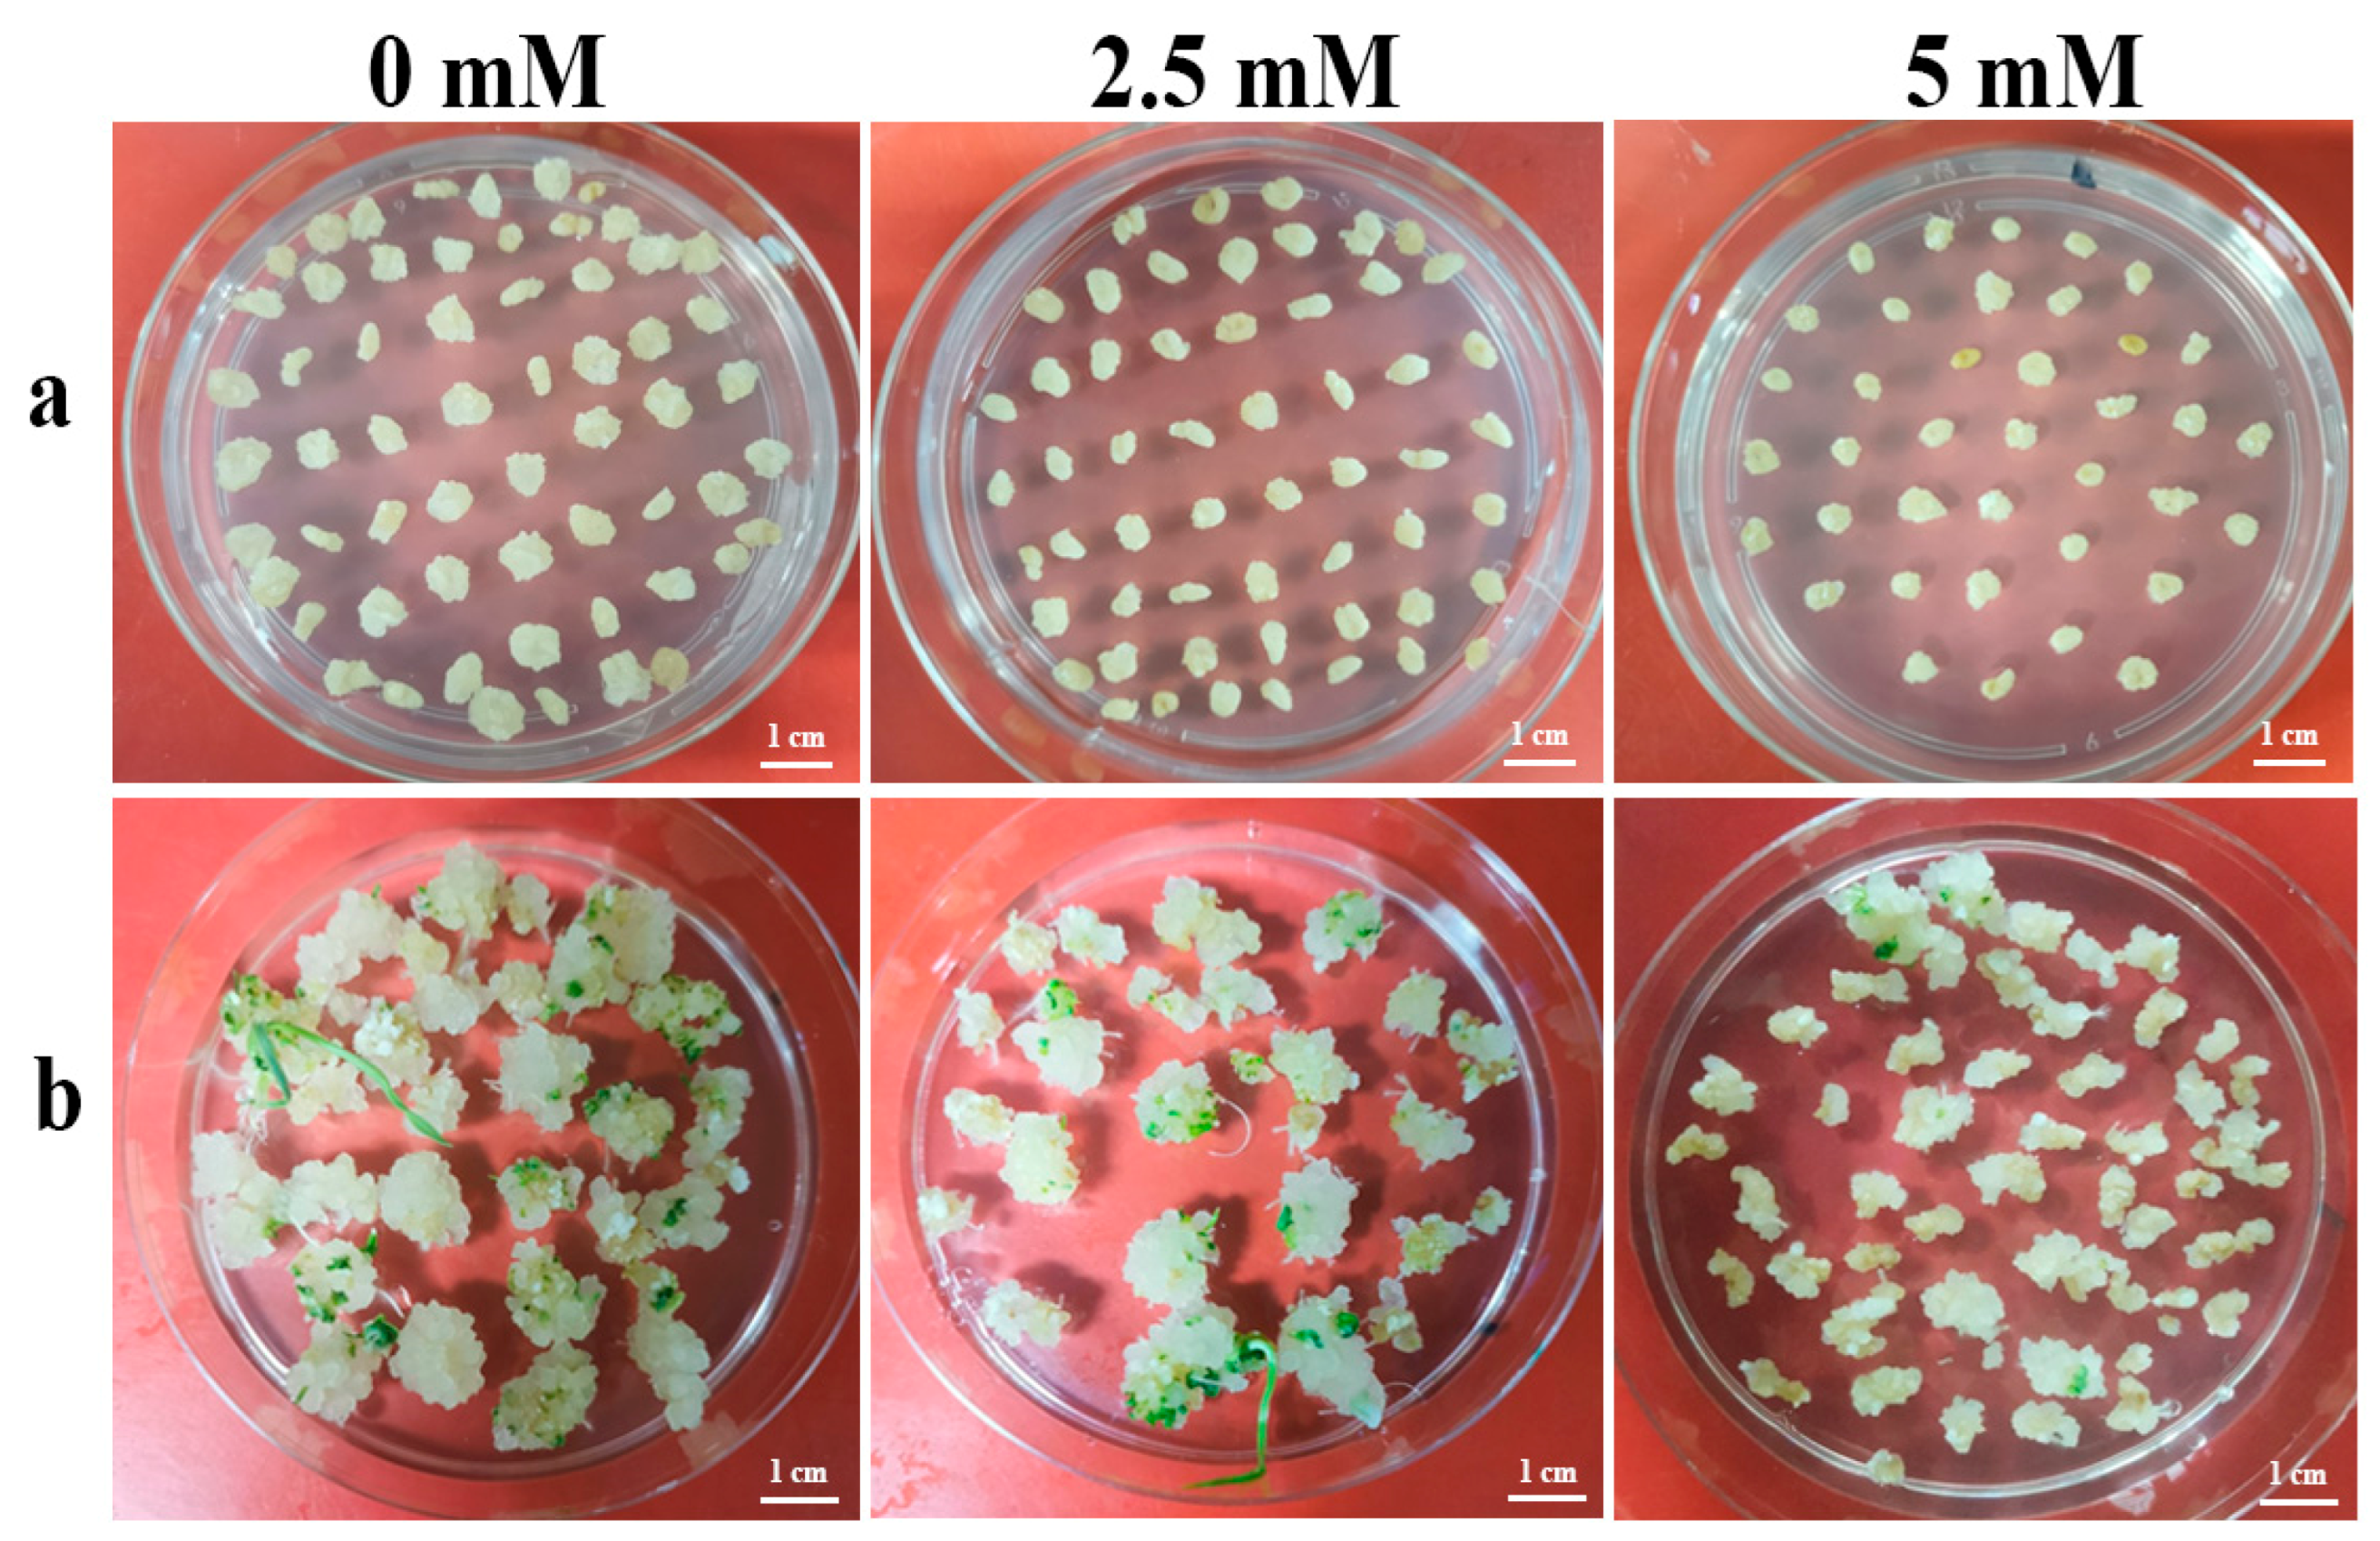

Application of Nicotinamide to Culture Medium Improves the Efficiency of Genome Editing in Hexaploid Wheat
Abstract
1. Introduction
2. Results
2.1. Effect of Nicotinamide Treatment of Transgenic Wheat Immature Embryos on the Mutation Efficiency of GUS Gene
2.2. Effect of Nicotinamide Treatment to Transgenic Wheat Immature Embryos on the Mutation Efficiency of TaWaxy Genes
2.3. Effects of Nicotinamide Treatment of Transgenic Mature Wheat Embryos on the Mutation Efficiency of TaWaxy Genes
2.4. Determination of Available Concentration of Nicotinamide Treatment during Wheat Genetic Transformation Steps
2.5. Application of Nicotinamide in Wheat Transformation for Improving Mutation Efficiency by Base Editing
3. Discussion
3.1. The Factors Affect the HDACi Treatment
3.2. Application Prospects of Nicotinamide in Wheat for Efficient Genome Editing
4. Materials and Methods
4.1. Plant Materials
4.2. Design of Wheat Mature and Immature Embryos with Nicotinamide Treatment
4.3. Detection of Mutations
4.4. Base Editing Vector Construction
4.5. Wheat Transformation
Supplementary Materials
Author Contributions
Funding
Institutional Review Board Statement
Informed Consent Statement
Data Availability Statement
Acknowledgments
Conflicts of Interest
References
- Cong, L.; Ran, F.A.; Cox, D.; Lin, S.; Barretto, R.; Habib, N.; Hsu, P.D.; Wu, X.; Jiang, W.; Marraffini, L.A.; et al. Multiplex genome engineering using CRISPR/Cas systems. Science 2013, 339, 819–823. [Google Scholar] [CrossRef]
- Mali, P.; Yang, L.; Esvelt, K.M.; Aach, J.; Guell, M.; DiCarlo, J.E.; Norville, J.E.; Church, G.M. RNA-guided human genome engineering via Cas9. Science 2013, 339, 823–826. [Google Scholar] [CrossRef] [PubMed]
- Walton, R.T.; Christie, K.A.; Whittaker, M.N.; Kleinstiver, B.P. Unconstrained genome targeting with near-PAMless engineered CRISPR-Cas9 variants. Science 2020, 368, 290–296. [Google Scholar] [CrossRef] [PubMed]
- Wang, K.; Gong, Q.; Ye, X. Recent developments and applications of genetic transformation and genome editing technologies in wheat. Theor. Appl. Genet. 2020, 133, 1603–1622. [Google Scholar] [CrossRef] [PubMed]
- Hu, J.H.; Miller, S.M.; Geurts, M.H.; Tang, W.; Chen, L.; Sun, N.; Zeina, C.M.; Gao, X.; Rees, H.A.; Lin, Z.; et al. Evolved Cas9 variants with broad PAM compatibility and high DNA specificity. Nature 2018, 556, 57–63. [Google Scholar] [CrossRef]
- Nishimasu, H.; Shi, X.; Ishiguro, S.; Gao, L.; Hirano, S.; Okazaki, S.; Noda, T.; Abudayyeh, O.O.; Gootenberg, J.S.; Mori, H.; et al. Engineered CRISPR-Cas9 nuclease with expanded targeting space. Science 2018, 361, 1259–1262. [Google Scholar] [CrossRef] [PubMed]
- Wang, M.; Mao, Y.; Lu, Y.; Tao, X.; Zhu, J.K. Multiplex Gene Editing in Rice Using the CRISPR-Cpf1 System. Mol. Plant 2017, 10, 1011–1013. [Google Scholar] [CrossRef]
- Liu, H.; Wang, K.; Jia, Z.; Gong, Q.; Lin, Z.; Du, L.; Pei, X.; Ye, X. Efficient induction of haploid plants in wheat by editing of TaMTL using an optimized Agrobacterium-mediated CRISPR system. J. Exp. Bot. 2020, 71, 1337–1349. [Google Scholar] [CrossRef]
- Wang, W.; Tian, B.; Pan, Q.; Chen, Y.; He, F.; Bai, G.; Akhunova, A.; Trick, H.N.; Akhunov, E. Expanding the range of editable targets in the wheat genome using the variants of the Cas12a and Cas9 nucleases. Plant Biotechnol. J. 2021, 19, 2428–2441. [Google Scholar] [CrossRef]
- Malzahn, A.A.; Tang, X.; Lee, K.; Ren, Q.; Sretenovic, S.; Zhang, Y.; Chen, H.; Kang, M.; Bao, Y.; Zheng, X.; et al. Application of CRISPR-Cas12a temperature sensitivity for improved genome editing in rice, maize, and Arabidopsis. BMC Biol. 2019, 17, 9. [Google Scholar] [CrossRef]
- Wu, X.; Scott, D.A.; Kriz, A.J.; Chiu, A.C.; Hsu, P.D.; Dadon, D.B.; Cheng, A.W.; Trevino, A.E.; Konermann, S.; Chen, S.; et al. Genome-wide binding of the CRISPR endonuclease Cas9 in mammalian cells. Nat. Biotechnol. 2014, 32, 670–676. [Google Scholar] [CrossRef] [PubMed]
- Zhang, Z.; Hua, L.; Gupta, A.; Tricoli, D.; Edwards, K.J.; Yang, B.; Li, W. Development of an Agrobacterium-delivered CRISPR/Cas9 system for wheat genome editing. Plant Biotechnol. J. 2019, 17, 1623–1635. [Google Scholar] [CrossRef] [PubMed]
- Campos, E.I.; Reinberg, D. Histones: Annotating chromatin. Annu. Rev. Genet. 2009, 43, 559–599. [Google Scholar] [CrossRef]
- Yarrington, R.M.; Verma, S.; Schwartz, S.; Trautman, J.K.; Carroll, D. Nucleosomes inhibit target cleavage by CRISPR-Cas9 in vivo. Proc. Natl. Acad. Sci. USA 2018, 115, 9351–9358. [Google Scholar] [CrossRef] [PubMed]
- Thurman, R.E.; Rynes, E.; Humbert, R.; Vierstra, J.; Maurano, M.T.; Haugen, E.; Sheffield, N.C.; Stergachis, A.B.; Wang, H.; Vernot, B.; et al. The accessible chromatin landscape of the human genome. Nature 2012, 489, 75–82. [Google Scholar] [CrossRef]
- Hinz, J.M.; Laughery, M.F.; Wyrick, J.J. Nucleosomes Inhibit Cas9 Endonuclease Activity in Vitro. Biochemistry 2015, 54, 7063–7066. [Google Scholar] [CrossRef]
- Horlbeck, M.A.; Witkowsky, L.B.; Guglielmi, B.; Replogle, J.M.; Gilbert, L.A.; Villalta, J.E.; Torigoe, S.E.; Tjian, R.; Weissman, J.S. Nucleosomes impede Cas9 access to DNA in vivo and in vitro. eLife 2016, 5, e12677. [Google Scholar] [CrossRef]
- Chari, R.; Mali, P.; Moosburner, M.; Church, G.M. Unraveling CRISPR-Cas9 genome engineering parameters via a library-on-library approach. Nat. Methods 2015, 12, 823–826. [Google Scholar] [CrossRef]
- Liu, G.; Yin, K.; Zhang, Q.; Gao, C.; Qiu, J.L. Modulating chromatin accessibility by transactivation and targeting proximal dsgRNAs enhances Cas9 editing efficiency in vivo. Genome Biol. 2019, 20, 145. [Google Scholar] [CrossRef]
- Hargreaves, D.C.; Crabtree, G.R. ATP-dependent chromatin remodeling: Genetics, genomics and mechanisms. Cell Res. 2011, 21, 396–420. [Google Scholar] [CrossRef]
- Cheung, W.L.; Briggs, S.D.; Allis, C.D. Acetylation and chromosomal functions. Curr. Opin. Cell Biol. 2000, 12, 326–333. [Google Scholar] [CrossRef] [PubMed]
- Bertos, N.R.; Wang, A.H.; Yang, X.J. Class II histone deacetylases: Structure, function, and regulation. Biochem. Cell Biol. 2001, 79, 243–252. [Google Scholar] [CrossRef] [PubMed]
- Liu, B.; Chen, S.; Rose, A.; Chen, D.; Cao, F.; Zwinderman, M.; Kiemel, D.; Aissi, M.; Dekker, F.J.; Haisma, H.J. Inhibition of histone deacetylase 1 (HDAC1) and HDAC2 enhances CRISPR/Cas9 genome editing. Nucleic Acids Res. 2020, 48, 517–532. [Google Scholar] [CrossRef]
- Davie, J.R. Inhibition of histone deacetylase activity by butyrate. J. Nutr. 2003, 133, 2485S–2493S. [Google Scholar] [CrossRef]
- Landry, J.; Slama, J.T.; Sternglanz, R. Role of NAD+ in the deacetylase activity of the SIR2-like proteins. Biochem. Biophys. Res. Commun. 2000, 278, 685–690. [Google Scholar] [CrossRef] [PubMed]
- Bitterman, K.J.; Anderson, R.M.; Cohen, H.Y.; Latorre-Esteves, M.; Sinclair, D.A. Inhibition of silencing and accelerated aging by nicotinamide, a putative negative regulator of yeast sir2 and human SIRT1. J. Biol. Chem. 2002, 277, 45099–45107. [Google Scholar] [CrossRef]
- Tiricz, H.; Nagy, B.; Ferenc, G.; Torok, K.; Nagy, I.; Dudits, D.; Ayaydin, F. Relaxed chromatin induced by histone deacetylase inhibitors improves the oligonucleotide-directed gene editing in plant cells. J. Plant Res. 2018, 131, 179–189. [Google Scholar] [CrossRef]
- Dai, W.; Liu, H.; Du, Q.; Zou, C.; Wang, K. Extension of the in vivo haploid induction system from diploid maize to hexaploid wheat. Biotechnol. Bull. 2021, 37, 2–14. [Google Scholar]
- Bond, D.M.; Dennis, E.S.; Pogson, B.J.; Finnegan, E.J. Histone acetylation, VERNALIZATION INSENSITIVE 3, FLOWERING LOCUS C, and the vernalization response. Mol. Plant 2009, 2, 724–737. [Google Scholar] [CrossRef]
- Zang, Y.; Gong, Q.; Xu, Y.; Liu, H.; Bai, H.; Li, N.; Du, L.; Ye, X.; Lan, C.; Wang, K. Production of Conjoined Transgenic and Edited Barley and Wheat Plants for Nud Genes Using the CRISPR/SpCas9 System. Front. Genet. 2022, 13, 873850. [Google Scholar] [CrossRef]
- Wei, C.; Wang, C.; Jia, M.; Guo, H.X.; Luo, P.Y.; Wang, M.G.; Zhu, J.K.; Zhang, H. Efficient generation of homozygous substitutions in rice in one generation utilizing an rABE8e base editor. J. Integr. Plant Biol. 2021, 63, 1595–1599. [Google Scholar] [CrossRef] [PubMed]
- Li, J.; Xu, R.; Qin, R.; Liu, X.; Kong, F.; Wei, P. Genome editing mediated by SpCas9 variants with broad non-canonical PAM compatibility in plants. Mol. Plant 2021, 14, 352–360. [Google Scholar] [CrossRef]
- Yan, D.; Ren, B.; Liu, L.; Yan, F.; Li, S.; Wang, G.; Sun, W.; Zhou, X.; Zhou, H. High-efficiency and multiplex adenine base editing in plants using new TadA variants. Mol. Plant 2021, 14, 722–731. [Google Scholar] [CrossRef] [PubMed]
- Ren, Q.; Sretenovic, S.; Liu, S.; Tang, X.; Huang, L.; He, Y.; Liu, L.; Guo, Y.; Zhong, Z.; Liu, G.; et al. PAM-less plant genome editing using a CRISPR-SpRY toolbox. Nat. Plants 2021, 7, 25–33. [Google Scholar] [CrossRef] [PubMed]
- Tan, J.; Zeng, D.; Zhao, Y.; Wang, Y.; Liu, T.; Li, S.; Xue, Y.; Luo, Y.; Xie, X.; Chen, L.; et al. PhieABEs: A PAM-less/free high-efficiency adenine base editor toolbox with wide target scope in plants. Plant Biotechnol. J. 2022, 20, 934–943. [Google Scholar] [CrossRef] [PubMed]
- Li, J.; Chen, L.; Liang, J.; Xu, R.; Jiang, Y.; Li, Y.; Ding, J.; Li, M.; Qin, R.; Wei, P. Development of a highly efficient prime editor 2 system in plants. Genome Biol. 2022, 23, 161. [Google Scholar] [CrossRef]
- Song, M.; Lim, J.M.; Min, S.; Oh, J.S.; Kim, D.Y.; Woo, J.S.; Nishimasu, H.; Cho, S.R.; Yoon, S.; Kim, H.H. Generation of a more efficient prime editor 2 by addition of the Rad51 DNA-binding domain. Nat. Commun. 2021, 12, 5617. [Google Scholar] [CrossRef]
- Wang, K.; Shi, L.; Liang, X.; Zhao, P.; Wang, W.; Liu, J.; Chang, Y.; Hiei, Y.; Yanagihara, C.; Du, L.; et al. The gene TaWOX5 overcomes genotype dependency in wheat genetic transformation. Nat. Plants 2022, 8, 110–117. [Google Scholar] [CrossRef]

| Groups | Nicotinamide Concentration (mM) | Treatment Time (d) | Plants Tested | bar-Positive | No. of Mutants | Editing Efficiency (%) |
|---|---|---|---|---|---|---|
| 2-G | 0 | 2 | 17 | 13 | 0 | 0 |
| 2-2.5-G | 2.5 | 2 | 28 | 21 | 0 | 0 |
| 2-5-G | 5 | 2 | 27 | 22 | 0 | 0 |
| 7-G | 0 | 7 | 25 | 15 | 0 | 0 |
| 7-2.5-G | 2.5 | 7 | 20 | 18 | 3 (He) | 16.7 |
| 7-5-G | 5 | 7 | 26 | 19 | 4 (He) | 21.1 |
| 14-G | 0 | 14 | 26 | 17 | 0 | 0 |
| 14-2.5-G | 2.5 | 14 | 36 | 25 | 8 (He) + 1 (Bi) | 36.0 |
| 14-5-G | 5 | 14 | 35 | 23 | 4He | 17.4 |
| Groups | Plants Tested | Bar-Positive Plants | Mutation Types at Different Locus on Chromosome | No. of Mutants | Editing Efficiency (%) | No. of the mutant Edited at One or Two Loci | |||
|---|---|---|---|---|---|---|---|---|---|
| 4A | 7A | 7D | 1 | 2 | |||||
| 14-W1 | 58 | 44 | 0 | 0 | 0 | 0 | 0 | 0 | 0 |
| 14-2.5-W1 | 71 | 53 | 2He (3.7%) | 3He (5.7%) | 5He (9.4%) | 7He | 13.2 | 4 (7.5%) | 3 (5.7%) |
| 14-5-W1 | 64 | 48 | 1He (2.1%) | 2He (4.1%) | 4He (8.4%) | 5He | 10.4 | 3 (6.3%) | 2 (4.2%) |
| Groups | Plants Tested | Bar-Positive Plants | Mutation Types at Different Locus on Chromosome | No. of New Mutants | Editing Efficiency (%) | No. of the Mutant Edited at Two or Three Loci | |||
|---|---|---|---|---|---|---|---|---|---|
| 4A | 7A | 7D | 2 | 3 | |||||
| 14-W2 | 15 | 12 | 1He (8.3%) | 0 | 0 | 1 | 8.3 | 1 (8.3%) | 0 |
| 14-2.5-W2 | 17 | 13 | 1He (7.7%) | 3He (23.1%) | 1He (7.7%) | 4 | 30.8 | 3 (23.1%) | 1 (7.7%) |
| 14-5-W2 | 10 | 8 | 1He (12.5%) | 1He (12.5%) | 0 0 | 2 | 25.0 | 2 (25%) | 0 |
| Groups | Plants Tested | Bar Positive Plants | Mutation Types at Different Locus on Chromosome | No. of Mutants | Editing Efficiency (%) | No. of the Mutant Edited at One or Two Loci | |||
|---|---|---|---|---|---|---|---|---|---|
| 4A | 7A | 7D | 1 | 2 | |||||
| 14-W3 | 24 | 21 | 0 | 0 | 0 | 0 | 0 | 0 | 0 |
| 14-2.5-W3 | 18 | 15 | 0 | 1He (6.7%) | 1He (6.7%) | 2 | 13.3 | 2 (13.3%) | 0 |
| 14-5-W3 | 9 | 8 | 0 | 1He (12.5%) | 0 | 1 | 12.5 | 1 (12.5%) | 0 |
| Vector | Nicotinamide Treatment (mM) | No. of Explants Transformed | No. of Positive Plants | Transformation Efficiency (%) |
|---|---|---|---|---|
| NGT2 | 0 | 57 | 53 | 92.98 |
| NGT2 | 2.5 | 55 | 30 | 54.55 |
| NGT2 | 5 | 38 | 7 | 18.40 |
| Vector | Nicotinamide Concentration (mM) | Target Loci | No. of Plants Identified | No. of Plants Edited | Mutation Efficiency (%) |
|---|---|---|---|---|---|
| ABENG-Wx | 0 | TaWaxy-A | 30 | 1 | 3.33 |
| TaWaxy-D | 0 | 0 | |||
| TaWaxy-AD | 0 | 0 | |||
| Total | 1 | 3.33 | |||
| ABENG-Wx | 2.5 | TaWaxy-A | 62 | 5 | 8.06 |
| TaWaxy-D | 2 | 3.23 | |||
| TaWaxy-AD | 2 | 3.23 | |||
| Total | 6 | 9.68 |
Disclaimer/Publisher’s Note: The statements, opinions and data contained in all publications are solely those of the individual author(s) and contributor(s) and not of MDPI and/or the editor(s). MDPI and/or the editor(s) disclaim responsibility for any injury to people or property resulting from any ideas, methods, instructions or products referred to in the content. |
© 2023 by the authors. Licensee MDPI, Basel, Switzerland. This article is an open access article distributed under the terms and conditions of the Creative Commons Attribution (CC BY) license (https://creativecommons.org/licenses/by/4.0/).
Share and Cite
Wang, W.; Huang, P.; Dai, W.; Tang, H.; Qiu, Y.; Chang, Y.; Han, Z.; Li, X.; Du, L.; Ye, X.; et al. Application of Nicotinamide to Culture Medium Improves the Efficiency of Genome Editing in Hexaploid Wheat. Int. J. Mol. Sci. 2023, 24, 4416. https://doi.org/10.3390/ijms24054416
Wang W, Huang P, Dai W, Tang H, Qiu Y, Chang Y, Han Z, Li X, Du L, Ye X, et al. Application of Nicotinamide to Culture Medium Improves the Efficiency of Genome Editing in Hexaploid Wheat. International Journal of Molecular Sciences. 2023; 24(5):4416. https://doi.org/10.3390/ijms24054416
Chicago/Turabian StyleWang, Wanxin, Peipei Huang, Wenshuang Dai, Huali Tang, Yuliang Qiu, Yanan Chang, Zhiyang Han, Xi Li, Lipu Du, Xingguo Ye, and et al. 2023. "Application of Nicotinamide to Culture Medium Improves the Efficiency of Genome Editing in Hexaploid Wheat" International Journal of Molecular Sciences 24, no. 5: 4416. https://doi.org/10.3390/ijms24054416
APA StyleWang, W., Huang, P., Dai, W., Tang, H., Qiu, Y., Chang, Y., Han, Z., Li, X., Du, L., Ye, X., Zou, C., & Wang, K. (2023). Application of Nicotinamide to Culture Medium Improves the Efficiency of Genome Editing in Hexaploid Wheat. International Journal of Molecular Sciences, 24(5), 4416. https://doi.org/10.3390/ijms24054416

